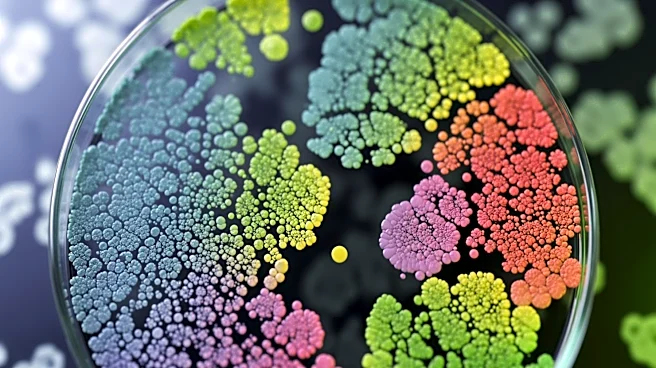
Distinct Microbial Signatures in Colorectal Cancer May Transform Treatment Approaches

What's Happening?
Researchers at the VCU Massey Comprehensive Cancer Center have developed a new targeted therapy that effectively prevents prostate cancer from spreading to the bones. The therapy, involving a small molecule inhibitor called IVMT-Rx-4, has shown promising
results in preclinical models by blocking the function of a gene known as MDA-9/syntenin, which is responsible for tumor growth and metastasis. This innovative approach not only halts the progression of prostate cancer to an advanced stage but also enhances the efficacy of existing chemotherapy treatments. The findings, published in Pharmacological Research, suggest a potential paradigm shift in treating metastatic prostate cancer.
Why It's Important?
Prostate cancer is a leading cause of cancer-related deaths among men in the U.S., particularly when it metastasizes to the bone. Current treatments often become ineffective at this stage, leading to severe health complications and reduced quality of life. The development of IVMT-Rx-4 offers a new therapeutic avenue that could significantly improve survival rates and quality of life for patients with advanced prostate cancer. By targeting the MDA-9/syntenin gene, this therapy addresses a critical unmet need in oncology, potentially transforming the standard of care for metastatic prostate cancer.
What's Next?
The research team plans to further evaluate the efficacy of IVMT-Rx-4 in clinical trials, with the aim of bringing this promising therapy to patients by 2027. Additionally, the team is exploring the development of a related drug, PDZ1i, which may offer even greater therapeutic benefits. These efforts are part of a broader strategy to identify and target key genetic drivers of cancer metastasis, paving the way for more effective and personalized cancer treatments in the future.